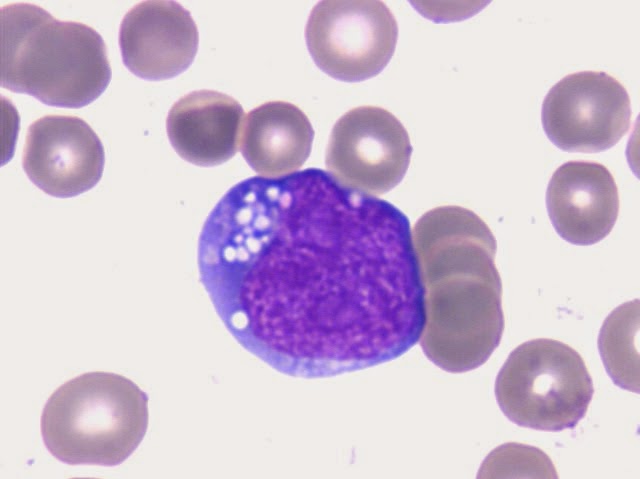

Causas: La hemoglobina se copone de dos proteínas: la globina alga y la globina beta. La talasemia ocurre cuando hay un defecto en un gen que ayuda a controlar la producción de una de estas proteínas.
Esisten dos tipos principales de talasemia:
- La talasemia alga ocurre cuando un gen o los genes relacionados con la proteína glovina alga faltan o han cambiado (mutado).
- La talasemia beta ocurre cuando defectos genéticos similares afecta la producción de la proteína globina beta.
Hay muchas formas de talasemia y cada tipo tiene muchos subtipos diferentes. Tanto la talasemia alfa como la beta abarcan las siguientes dos formas:
- Talasemia mayor
- Talasemia menor
Es necesario heredar el gen defectuoso de ambos padres para padecer la talasemia mayor.
La talasemia menor se presenta si uno recibe el gen defectusos de solo uno de los padres. Las personas con esta forma de trastornos son portadores de enfermedad y por lo regular no tienen síntomas.
La talasemia beta mayor también se denomina anemia de Cooley.
Síntomas:
La forma más grave de talasemia alfa mayor causa mortinato (muerte de bebé nonato durante el parto o en las ultimas etapas del embarazo).
Los niños nacidos con talasemia mayor (anemia de Cooley) son normales en el nacimiento, pero desarrollan anemia graves durante el primer año de vida.
Las personas con la forma menor de talasemia alfa y beta tienen glóbulos rojos pequeños, pero no presentan ningún síntoma.
Tratamiento:
El tratamiento para la talasemia mayor a menudo implica transfusiones de sangre regular y suplementos de folato.
No tomar suplementos de hierro si se ha realizado a un paciente una transfusión.
Las personas que reciben muchas transfusiones requieren un tratamiento llamado terapia de quelación, la cual se hace para eliminar el exceso de hierro del cuerpo.
Un trasplante de médula ósea puede ayudar a tratar la enfermedad en algunos pacientes, especialmente niños.
Referencias Bibliográficas:
Arribas, J. (2005) Hematología Clinica Tema de patología medica. España; Editorial Texto Universitario Ediuno.
Manascero, A. (2003). Hematóloga, herramientas para el diagnostico. Atlas de morfología celular, alteraciones y enfermedades relacionadas. (1a. Ed) Bogota, Colombia; Javiero.